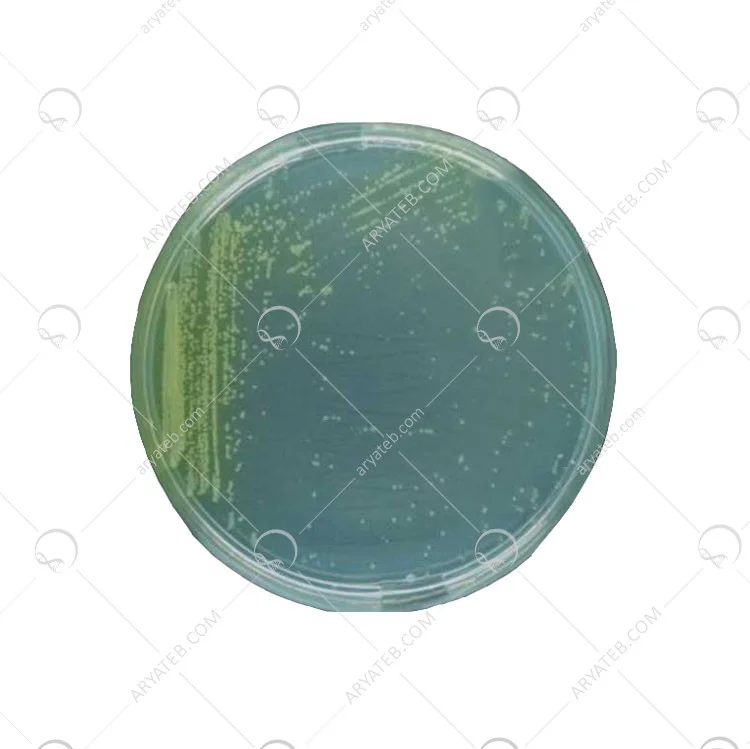
محیط کشت کینگ بی

محیط کشت کینگ بی
محیط کشت کینگ بی آگار
محیط کشت (King's B) که به اختصار محیط کشت KB نیز نامیده می شود، یک محیط غیر انتخابی است که برای جداسازی ایزوله های مشکوک استفاده می شود. افزودن آنتی بیوتیک هایی مانند سفالکسین سودوموناس سیرینگه pv است. King's B یک رسانه غیر انتخابی است و برای جداسازی جزئی استفاده می شود. افزودن آنتی بیوتیک هایی مانند سفالکسین سودوموناس سیرینگه pv است.
محیط کشت کینگ
محیط کشت KB از چه عناصری تشکیل شده است
- مواد لازم 1 لیتر 500 میلی لیتر
- آب مقطر 1 لیتر 500 میلی لیتر
- پروتئوز پپتون شماره 3 (Difco) 20 گرم 10 گرم
- K2HPO4 1.5 گرم 0.75 گرم
- MgSO4·7H2O 1.5g 0.75g
- گلیسرول 10 میلی لیتر 5 میلی لیتر
- آگار 15 گرم 7.5 گرم
محیط کشت king B agar
دستورالعمل ها محیط کشت KB
- ابتدا آب و پپتون را مخلوط کنید.
- بجوشانید و ذوب کنید
- مواد شیمیایی دیگر را اضافه کنید
- حرارت دهید تا همه ذوب شوند.
محیط کشت king b
این محیط بهترین محیط جداسازی عمومی برای باکتری ها است. سودومونادهای فلورسنت رنگدانه های زرد رنگی تولید می کنند که در نور فرابنفش با طول موج بلند (366 نانومتر) فلورسان می کنند. برخی از جدایه های گروه P. syringae فلورسانس نمی کنند.
این محیط ممکن است برای نگهداری طولانی مدت اروینیا (بیش از 2 روز) مناسب نباشد. زیرا برخی ممکن است در عرض چند روز تا یک هفته بمیرند.
استفاده از پروتئین پپتون شماره 3 و نه پپتون های دیگر مهم است تا کلنی ها بتوانند فلوروکروم تولید کنند.
این مخلوط به صورت تجاری Difco Pseudomonas agar F نیز موجود است.
آدرس ایمیل شما منتشر نخواهد شد. فیلدهای الزامی علامت گذاری شده اند *